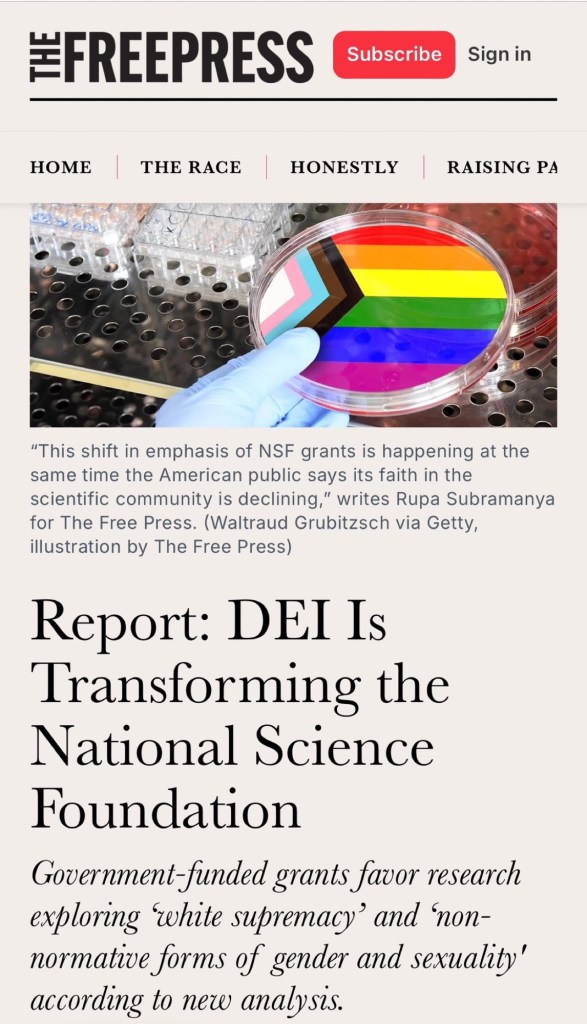

Fri October 11th 2024
Zelenskyy and the NATO war hawks, and the war criminal Netanyahu, are demanding a bigger war, when the wars are already lost. Shall all mankind be sacrificed on the altar built by ego and delusion? More voices are speaking out for diplomacy, and for cooperation for mutual benefit. How about you? Are you willing to risk all for the benefit of the billionaires who profit from war and neo-colonial looting? If not, be sure to join the International Peace Coalition Zoom call this Friday at 11 AM eastern time.
Link to this week’s dialogue with Helga Zepp-LaRouche:
schillerinstitute.com/blog/2024/10/0…
Link to interview with Dr. Mahathir Muhamad, former Prime Minister of Malaysia:
schillerinstitute.com/blog/2024/10/0…
For Friday questions, send your questions and comments to me at:
harleysch@gmail.com
===LaRouche Org
OUCH: Stephen Colbert just got exposed a complete hypocrite in a viral clip.
This is glorious.
Before the 2020 election, Colbert claimed it was immoral to vote for Trump, pointing to his administration losing track of 545 migrant kids.
But now? The Biden-Harris admin has lost track of hundreds of thousands of migrant children, many of whom have been sold into labor and s*x trafficking.
And for some reason, Colbert didn’t think it was important enough to mention while sipping beer with Kamala Harris on his show. Weird.
Shout-out to @mazemoore for putting this devastating clip together.
===Vigilant News
🚨SINCE KAMALA TOOK OFFICE
Gas: +38.2%
Electricity: +31.3%
Fuel oil: +37.4%
Airfare: +24.5%
Hotels: +42.4%
Groceries: +22.1%
Eggs: +69.2%
Baby food: +31%
K-12 food: +69.7%
Rent: +22.9%
Transportation: +31.1%
Car insurance: +56.5%
Real average weekly earnings: -3.4%
===Jacki Kotkiewicz

PRESIDENT TRUMP: “Kamala’s EV mandate is one of the most demented regulations that’s been conceived— It will destroy U.S. auto manufacturing immediately, destroy our trucking-based supply chain, destroy our electric grid, destroy our military, destroy our roads and bridges with vehicles that are far too heavy, destroy the state of Michigan, and destroy the Middle Class.”
===Trump War Room
All as planned by Deep State [DS] USA Inc. aka Feds [CIA MI6 City of London] for destruction of Constitutional America & American Citizens. All by design. Kamala couldn’t think such an evil thing all by her malignantly moronic self [DS] Teleprompter script is Kamala’s brain.
===crp
Prior to Biden taking office in 2020, less than 1% of @NSF grants were related to DEI. Now that number exceeds 10%. These grants prioritize aspects other than scientific merit, and subsidize woke ideology with taxpayer dollars.
@rupasubramanya reports ⬇️
thefp.com/p/dei-national…
===Colin Wright
Do not trust “the experts.”
The Left is corrupting so-called “science organizations” to ram through their Marxist DEI agenda.
Kamala Harris and Joe Biden continue to defraud the American taxpayer with this garbage.
===Steve Cortes
Re: Kamala Admin DEI Hiring Quotas. It’s about FEMA hiring DEI for the Government Jobs Bureaucracy with six digit $ incomes and absolutely nothing of service to the American Citizen Taxpayers who are paying for these pseudo service jobs. It’s all about the MONEY!
===crp
Can we call this foreign election interference?
===Resist the Mainstream

He would have liked it if it went up his derriere!
Anderson Cooper Hit In The Face By Flying Debris While Covering Hurricane Milton Live For CNN
===Larry Klayman
Whoopie Goldberg is a treasonously vile malignant criminally insane PoS; an obscene specter of hate personified. That’s patently clear enough to anyone with a modicum of common sense. It’s time to clean out this garbage.
===crp
FEMA is quietly paying private security firms massive amounts of money to keep Floridians from returning to their homes and businesses after a hurricane.
The evacuation orders are more than just precautionary—they’re part of a larger plan to lock people out of the state.
Delta Force is advising FEMA, preparing enforcement tactics that could involve force if necessary.
With tensions expected to rise as displaced residents try to return, FEMA is said to be scrambling to get enough armed personnel on the ground.
@ShadowofEzra
Hurricane Milton floods Disney World in Orlando, Florida, prompting the park to remain closed until Thursday, with possible closures extending into the weekend.
===Shadow of Ezra

Everything on MSM Mockingbird Networks is a lie. All truth is twisted w/inversions & contorted into scripted projections of gaslighting narratives. DISINFO is what they do. You can’t reason w/this psycho-political insanity b/c they’re living in a fake reality of their own device.
===crp
Deep State [DS CIA MI6 City of London] “DISINFO OP” by Demonic-Rats & Uni-Party RINOs SPOX Flat Out Lie to The American People w/[DS] scripted MSM Mockingbird Fake News & SM N/Ws in order to get “Disinformation Programming” into Public Mindsets before any “Fact Checking” is done.
===crp
Deep State [DS = CIA MI6 City of London] “Project Mockingbird” is known as MSM [Hollywood ABC NBC CBS AP MSNBC CNN PBS NPR Radio & TV] SM “Fake News” w/ “Fake Commentary” = DISINFO HQ! All [DS] scripted Lies w/Gaslighted Projections based upon a precedence of [DS] scripted Lies.
===crp
All KJP knows how to do is lie & lie to the American People. That’s KJP’s WH Job #1 = Deceive the American People about everything. Rule of Thumb = When KJP declares facts & truth categorically false & not true = it’s a Deep State Code signaling what is actually true in fact.

Illuminati game created in 1994. It’s playing right now in real time on the world stage. The next card : hurricane, Watch the water. The last card will be the aliens coming from the water. That will be the end of the game.
===Qmum

Globalist UN WEF NWO “Acts of War” 5GW against American People. If this Enemy of the People can’t Burn & Smoke Townspeople out, then Storm Flood & Quake, or Killer Plague mRNA Vax & Poison, or Starve the People out & Invade Towns w/hordes of Illegal Immigrants & Enemy Combatants.
===crp
Smirking Serially Lying Barack Obama is a malignant treasonous criminally insane obscenity w/nothing but contempt for American People and the Constitution. He’s a Deep State [CIA MI6] “implant” into the American Political Culture for which “democracy” is a psycho-political scam.
===crp
Cackling Kamala Harris is a Low IQ (idiot) malignantly treasonous criminally insane psycho-political obscenity who is whatever she imagines herself to be. A psychotic Deep State Clown Show. “Marxist” is too big a word for her. She’s whatever her DNC teleprompter tells her to be.
===crp
Biden tells Trump to “get a life” and “help these people” in North Carolina — then walks out of the room.
Does Biden think Trump is currently president?
===johnny maga
Kamala and Biden left scores of North Carolina citizens to suffer and drown. Families. Children. North Carolina has Military bases everywhere — but for days and days no one was sent to save these precious souls. Kamala abandoned them. Unforgivable.
===Stephen Miller
🚨Kamala Harris EXPOSED for ordering the National Guard to load a C-17 cargo plane with relief supplies supposedly for victims of the Hurricane in North Carolina for a photo op but NEVER SENT the plane.
===Benny Johnson
Here’s just one item of scores of items demonstrating Donald Trump’s commitment to helping the communities victimized and all but destroyed by Hurricane Helene and those devastated by Hurricane Milton. What has Biden’s admin done in kind? Absolutely nothing but criticize the People’s and Trump’s responses. Not only “nothing” but even actively sabotaged those community efforts.
===crp

Aaron Switzer, Retired Air Force Special Operations, Swannanoa, North Carolina
He was on the ground and confirms FEMA blocked aircraft/ helicopters from bringing in aid.
He even confirms FEMA blocked State Patrol helicopters
Kamala Harris FEMA shut everyone down
“So the big thing was we started to have an increase of state helicopters coming into this direction, primarily because the old HLZ that they had established, FEMA took over and basically took charge of it and then wouldn’t allow anything but their assets to fly in there to include state patrol. They were denied.”
===Wall Street Apes
America is choosing Trump
“You want to know how I know I’m choosing the right candidate in November?”
“While devastation continues to wreak havoc in America, your candidate is having a beer on a talk show and the guy I’m voting for is housing 275 lineman in Florida for free.”
SPOT ON 🔥🔥🔥🔥
===TONYxTWO
Carville says Kamala needs to get ‘more aggressive’ and stop answering questions…What exactly has she answered? All we know from Kamalas media blitz is she drinks Miller High Life and defends dem policies that have destroyed the working class. Newsflash Dems: a clear, focused, and articulated vision for America is necessary in order for Americans to even understand you.
foxnews.com/video/63630716…
===Jeanine Pirro
Cackling Kamala Harris is obviously extremely Low IQ = a very malignantly stupid psycho-political creature which translates into someone who has no idea what she’s talking about as a matter of fact; and whatever Kamala is talking about is an incessant load of obscene nonsense for anyone who can relate to that.
===crp
Xv.
Cackling Kamala Harris is obviously v. Low IQ = a malignantly stupid psycho-political creature = someone who has no idea what she’s talking about as a matter of fact; and whatever Kamala is talking about = a load of obscene nonsense for anyone w/v. Low IQ who can relate to that.
===crp

OUT NOW: James O’Keefe’s documentary, “Line in the Sand,” documents the border crisis like you’ve never seen it before—riding Mexican freight trains, exploring cartel tunnels, and visiting U.S.-funded child detention camps.
Watch it now at TuckerCarlson.com/lineinthesand.
Kamala Harris said she wouldn’t have done anything differently than Joe Biden.
It is grotesquely arrogant to say she wouldn’t have changed anything about the disastrous withdrawal from Afghanistan that cost the lives of 13 American Servicemembers.
podcasts.apple.com/us/podcast/ill…
===Ted Cruz
President Trump says CBS should lose its license for selectively editing Kamala Harris’s answers to “protect her” on 60 Minutes:
“I think she’s dumber than hell … They change her answer, they take it out, throw it away and put in a totally different answer in order to protect her, and they get caught. CBS should lose their license.”
===Charlie Kirk

Tim Walz claims “voters focusing on immigration helps” their campaign because President Trump — who oversaw the most secure border in history — “wasn’t doing anything about it.”
He claims Kamala is “leaning into it” after she let 20+ million illegals invade the country.
===Trump War Room
Daily Mail reports migrant hotel rooms cost $325 PER NIGHT.
===Resist the Mainstream

It wasn’t “after riots by his (DJT) supporters” it’s after riots instigated by Nancy Pelosi’s False Flag Plot w/100’s of FBI and ANTIFA BLM agent provocateurs inserted into DJT’s “Peaceful Demonstrators” orchestrating a deadly riot to smear and prosecute DJT on false charges.
===crp

🔥 Russia Announces They Have Evidence US and UK Were Behind Nord Stream Pipeline Bombings
Remember when U.S. officials repeatedly said they wanted to get rid of the Nord Stream pipeline, and then U.S. media tried to blame Russia for blowing up its own pipeline?
@ggreenwald on a new report about the U.S. role in the Nord Stream pipeline explosion:
===System Update
🔥 Russia Announces They Have Evidence US and UK Were Behind Nord Stream Pipeline Bombings
Re: Nord Steam Blowup. Another Deep State [CIA MI6 FBI DOJ] USA Inc. [City of London Corp.] False Flag Plot exposed like JFK assassination 9/11 WTC demolition J6 FBI + ANTIFA BLM instigated Capital Riots and the latest DJT assassination “attempts”.
All Fed Orchestrated False Flag Ops. MSM complicit.
===crp
🚨 MAJOR POLICY ALERT‼️
Trump just announced that he will make Interest on Car Loans FULLY Deductible
This is going to REVOLUTIONIZE the Auto Industry. This will stimulate massive domestic auto production and make car ownership dramatically more affordable.
===Charlie Kirk
This is Uruguay:
– 0% tax on foreign income for 11 years
– Permanent residency in just 2 years
– Less corrupt than the US
It is the safest country in South America.
Here are 11 reasons why the “Switzerland of South America” is a hidden gem:
===Alessandro Palombo
